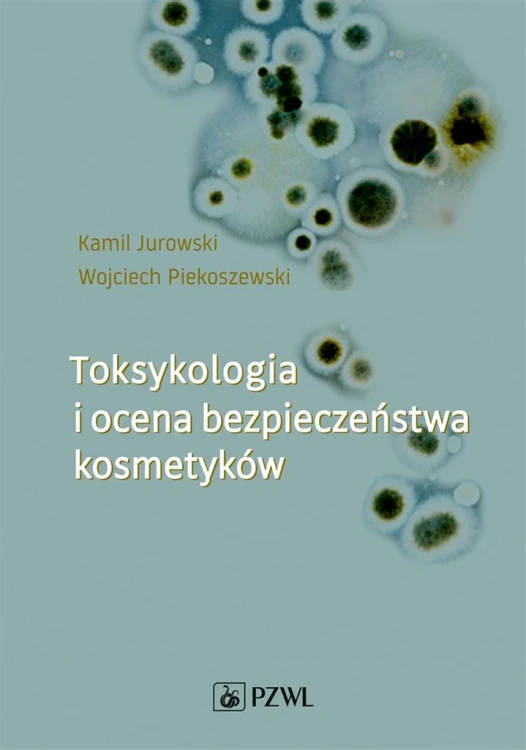
Toksykologia i ocena bezpieczeństwa kosmetyków

TOKSYKOLOGIA I OCENA BEZPIECZEŃSTWA KOSMETYKÓW
KAMIL JUROWSKI, WOJCIECH PIEKOSZEWSKI, PZWL, 2019, 9788320056853
Książka, jakiej jeszcze nie było na polskim rynku wydawniczym! Autorzy w sposób kompleksowy przedstawiają aspekty zarówno teoretyczne, jak i praktyczne w zakresie toksykologii i oceny bezpieczeństwa kosmetyków. Całość podzielono na trzy części: podstawy toksykologii ogólnej, toksykologię kosmetyków...
Kod produktu: 9788320056853
Opis
Książka, jakiej jeszcze nie było na polskim rynku wydawniczym! Autorzy w sposób kompleksowy przedstawiają aspekty zarówno teoretyczne, jak i praktyczne w zakresie toksykologii i oceny bezpieczeństwa kosmetyków. Całość podzielono na trzy części: podstawy toksykologii ogólnej, toksykologię kosmetyków i ocenę bezpieczeństwa. Niezbędnik dla studentów kosmetologii, chemii kosmetycznej, chemii, biochemii, biotechnologii oraz dermatologów, alergologów, poczatkujących safety assessorów i praktyków.
| AUTOR | KAMIL JUROWSKI, WOJCIECH PIEKOSZEWSKI |
| TYTUŁ | TOKSYKOLOGIA I OCENA BEZPIECZEŃSTWA KOSMETYKÓW |
| WYDAWCA | PZWL |
| ROK WYDANIA | 2019 |
| OPRAWA | OPRAWA BROSZUROWA |
| ILOŚĆ STRON | 465 |
| EAN | 9788320056853 |